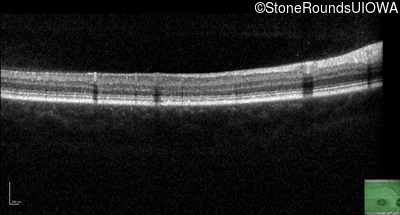
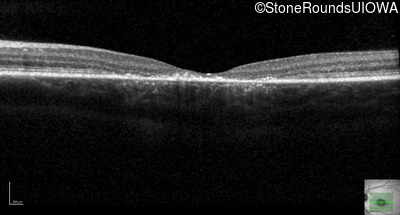
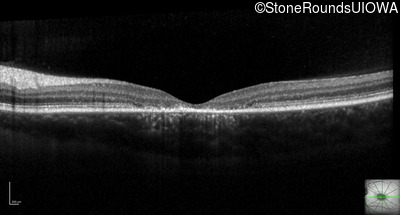
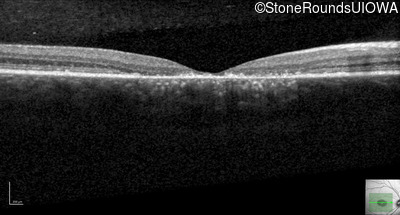
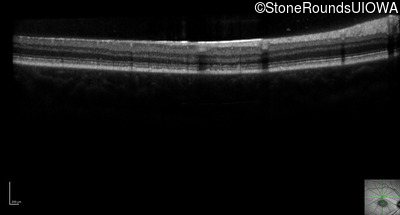
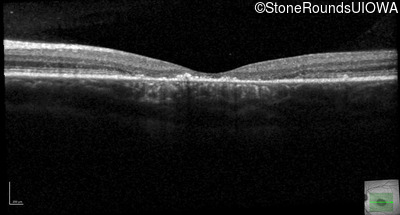
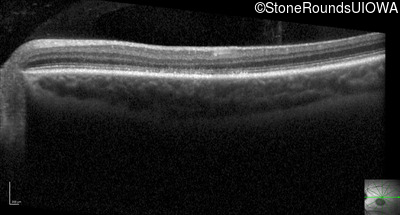
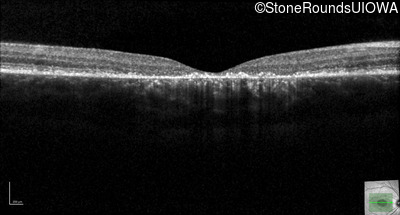
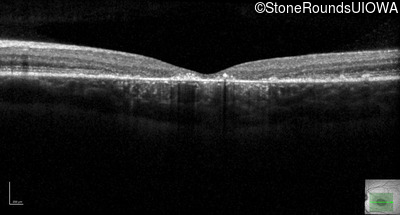
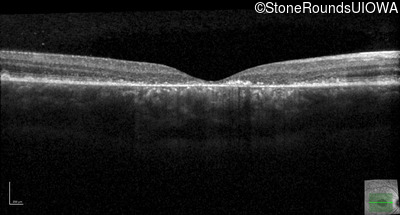
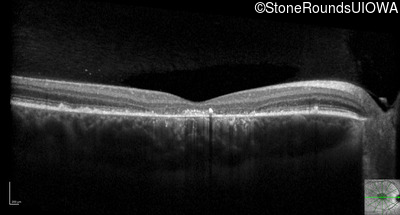
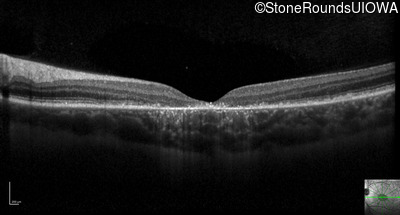

Case
SR2584
Student Mode
AR Stargardt Disease (IIA)
Male
Male
Hidden
SR2584
Student Mode
AR Stargardt Disease (IIA)
Male
Male
Please Login or Register to download images or create a PowerPoint slideshow.
Visit at age: 10 years
Fundus Photography - Right - 20/125 sc
Exemplar

Fundus Photography - Left - 20/125 sc
Exemplar

Fundus Montage - Right - 20/125 sc
Exemplar

Fundus Montage - Left - 20/125 sc
Exemplar

Goldmann Visual Field - Right - 20/125 sc
Exemplar

Goldmann Visual Field - Left - 20/125 sc
Exemplar

Optical Coherence Tomography - Right - 20/125 sc
Exemplar / OCT Stack

OCT Stack

OCT Stack

Optical Coherence Tomography - Left - 20/125 sc
Exemplar / OCT Stack

OCT Stack

OCT Stack

Infrared Fundus Photograph - Right - 20/125 sc
Exemplar

Infrared Fundus Photograph - Left - 20/125 sc
Exemplar

Blue Autofluorescence - Right - 20/125 sc
Exemplar

Blue Autofluorescence - Left - 20/125 sc
Exemplar

Visit at age: 11 years
Goldmann Visual Field - Right - 20/125 sc
Exemplar

Goldmann Visual Field - Left - 20/125 sc
Exemplar

Optical Coherence Tomography - Right - 20/125 sc
Exemplar / OCT Stack

OCT Stack

Optical Coherence Tomography - Left - 20/125 sc
Exemplar / OCT Stack

OCT Stack

Infrared Fundus Photograph - Right - 20/125 sc
Exemplar

Infrared Fundus Photograph - Left - 20/125 sc
Exemplar

Blue Autofluorescence - Right - 20/125 sc
Exemplar

Blue Autofluorescence - Left - 20/125 sc
Exemplar

Visit at age: 12 years
Optical Coherence Tomography - Right - 20/160 -1 sc
Exemplar / OCT Stack

OCT Stack

Optical Coherence Tomography - Left - 20/160 -1 sc
Exemplar / OCT Stack

OCT Stack

Infrared Fundus Photograph - Right - 20/160 -1 sc
Exemplar

Infrared Fundus Photograph - Left - 20/160 -1 sc
Exemplar

Visit at age: 13 years
Optical Coherence Tomography - Right - 20/200 +2 sc
Exemplar / OCT Stack

OCT Stack

OCT Stack

Optical Coherence Tomography - Left - 20/160 -2 sc
Exemplar / OCT Stack

OCT Stack

OCT Stack

Infrared Fundus Photograph - Right - 20/200 +2 sc
Exemplar

Infrared Fundus Photograph - Left - 20/160 -2 sc
Exemplar

Case Level Images
Please Login or Register to download images or create a PowerPoint slideshow.